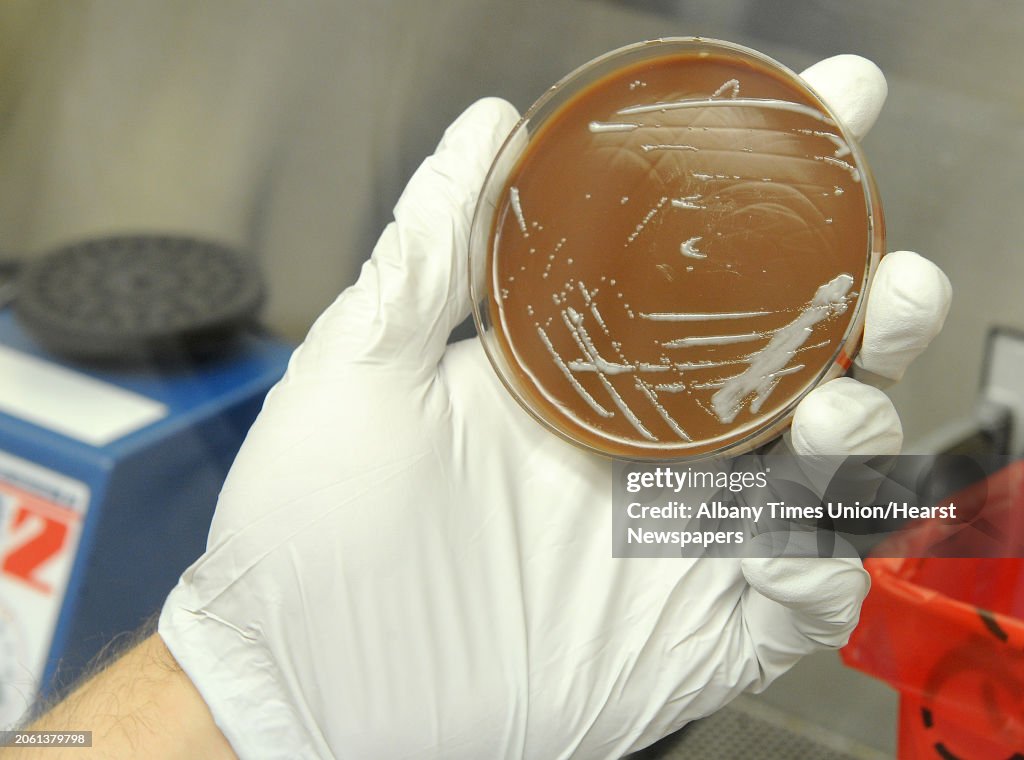

Albany Times Union
PhD. student Brian Franz holds Francisella Tularensis bacteria growth on a chocolate agar plate under a hood in a lab where research is done on vaccines at Albany Medical College on Monday, Sept. 9, 2013 in Albany, N.Y. (Photo by Lori Van Buren/Albany Times Union via Getty Images)
ACHETER UNE LICENCE
Comment puis-je utiliser cette image ?
385,00 €
EUR
Getty ImagesAlbany Times Union, Photo d'actualité
Albany Times Union Obtenez des photos d'actualité haute résolution de qualité sur Getty ImagesProduct #:2061379798

475€175€
Getty Images
In stockINFORMATIONS
Restrictions :
Contactez votre agence locale pour toute utilisation commerciale ou promotionnelle.
Crédits :
Editorial - n° :
2061379798
Collection :
Hearst Newspapers
Date de création :
9 septembre 2013
Date de chargement :
Type de licence :
Infos autorisations :
Autorisation non disponible. Plus d'infos
Source :
Hearst Newspapers
Référence :
0910_vaccines
Taille max. de fichier :
4000 x 2970 px (33,87 x 25,15 cm) - 300 dpi - 4 MB